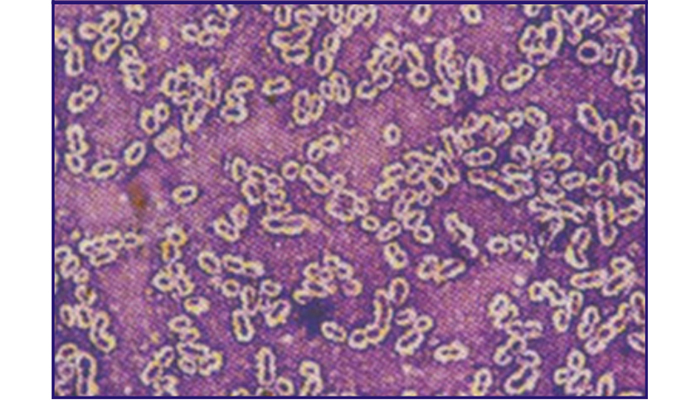

Bacterial Capsule Stain

Principle:
Capsule is a characteristic mucous substance developed external to but contagious with the cell wall during bacteria's life cycle. The capsule can protect bacteria from phagocytosis and subsequent digestion by their host, thus increasing their infectivity. Capsules can only be stained with certain special stains. Identification of capsules is very important for bacteria grouping and differentiation.
Specifications:
|
Contents |
2vials×20ml/Kit |
Components |
| Crystal violet stain |
1vial×20ml |
Crystal violet |
| Bluestone solution |
1vial×20ml |
Bluestone |
Methods:
1. Take a clean slide and prepare smear of bacterium which is suspected to have capsules. Air dry and fix in
ethanol.
2. Add Crystal violet stain, then heat on flame and keep dye steaming for about 1min.
3. Wash dyes on the smear with 200g/L Bluestone solution (avoid washing with water).
4. Dry with absorbent paper and observe under oil immersion lens.
Precaution:
1. As water represents 90% of the capsule contents, do not fix samples by heating or capsules will shrink.
2. After staining, samples must be washed with 200 g/L Bluestone solution instead of water.